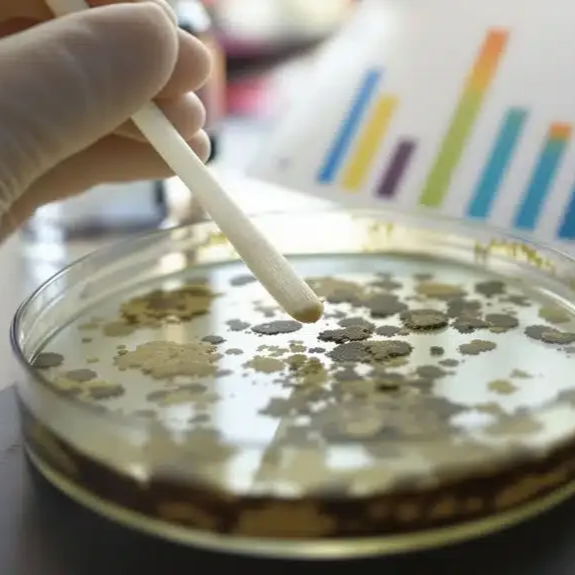

Book Your Home Inspection in Under 60 Seconds
Top- Rated • Licensed & Insured • Same-Day Reports • Flexible Scheduling
Serving DC • Maryland • Virginia • Eastern Shore
Available 24/7 — Call Now or Book Instantly Online
⭐⭐⭐⭐⭐
top-rated by DMV Homebuyers
★★★★★ “Extremely thorough and caught issues we would have never noticed.” — Homebuyer, DC
★★★★★ “Fast, professional, and incredibly detailed inspection.” — Client, Northern VA
★★★★★ “Saved us thousands by finding a hidden issue before closing.” — Buyer, MD
★★★★★ “Explained everything clearly and answered every question.” — Homebuyer, MD
★★★★★ “Very thorough, patient, and easy to work with.” — Client, VA
★★★★★ “Report was clear, detailed, and delivered quickly.” — Homebuyer, MD
★★★★★ “Smooth, professional process from start to finish.” — Client, DC
★★★★★ “Extremely thorough and caught issues we would have never noticed.” — Homebuyer, DC ★★★★★ “Fast, professional, and incredibly detailed inspection.” — Client, Northern VA ★★★★★ “Saved us thousands by finding a hidden issue before closing.” — Buyer, MD ★★★★★ “Explained everything clearly and answered every question.” — Homebuyer, MD ★★★★★ “Very thorough, patient, and easy to work with.” — Client, VA ★★★★★ “Report was clear, detailed, and delivered quickly.” — Homebuyer, MD ★★★★★ “Smooth, professional process from start to finish.” — Client, DC



✔ Same-Day Reports
✔ Fast, Flexible Scheduling
✔ Licensed & Insured
✔ Serving DMV & Eastern Shore
what you get with every inspection:
✔ Full Residential Home Inspection
✔ Detailed Same-Day Report
✔ Clear, Easy-to-Read Findings
✔ Fast, Flexible Scheduling
✔ Photos and Documentation Included
✔ Optional Add-Ons Available
Full Residential Home Inspection
$395+
Comprehensive evaluation of all major systems including roof, electrical, plumbing, HVAC, and structure.
Delivered with a clear, easy-to-read same-day report.
▾ View pricing details ▾
mold/air quality testing
$245
Identify mold and indoor air quality concerns that could impact health and long-term property condition.
Recommended during residential transactions on houses with basements.
well/Water quality testing
$195
Ensure your water is safe by testing for contaminants and verifying overall water quality.
Recommended during residential transactions on houses with well water.
termite/WDI Inspection
$75
Check for wood-destroying insects such as termites and hidden damage that could compromise the home’s structure.
Recommended during residential transactions on houses in wooded areas.
radon emission Inspection
$175
Detect harmful radon levels in the home to protect your health and ensure a safe living environment.
Recommended during residential transactions on houses with basements.
septic/sewer scope Inspection
$595
Evaluate the condition of the septic or sewer system and detect potential issues before they become costly problems.
Recommended during residential transactions on houses with septic tanks.
Not sure what you need?? Call or text us and we’ll guide you.

Schedule YOUR INSPECTION TODAY
Schedule your property inspection today with our expert team to ensure a thorough evaluation and peace of mind. Our dedicated professionals are ready to assist you with timely and accurate assessments.